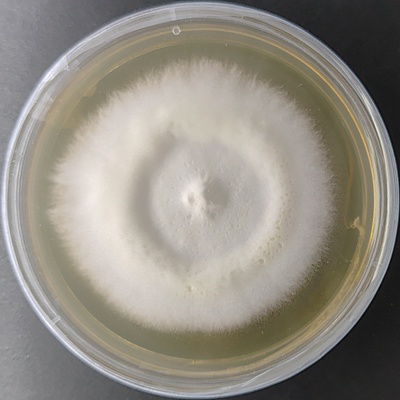
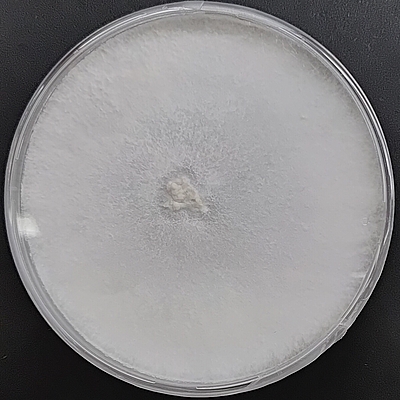
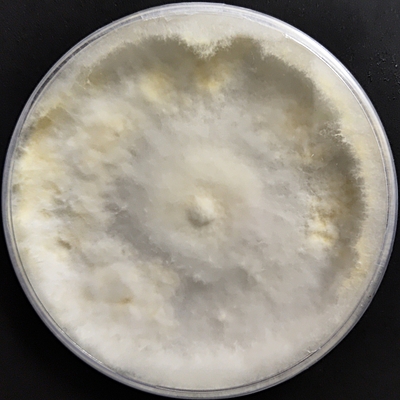
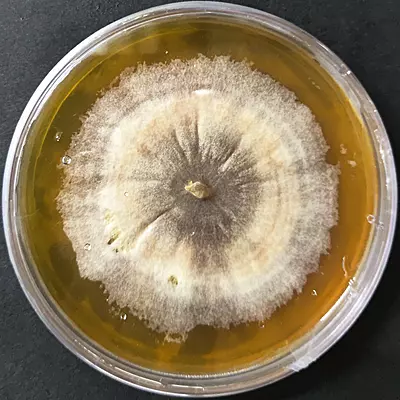
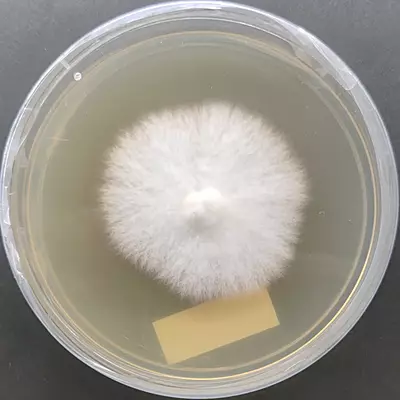
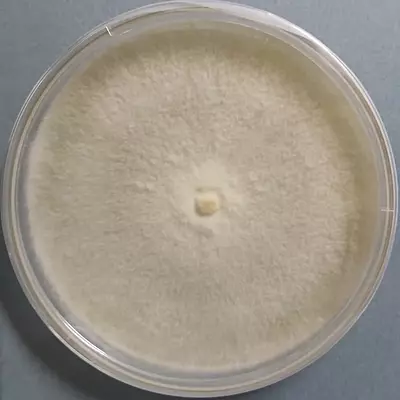
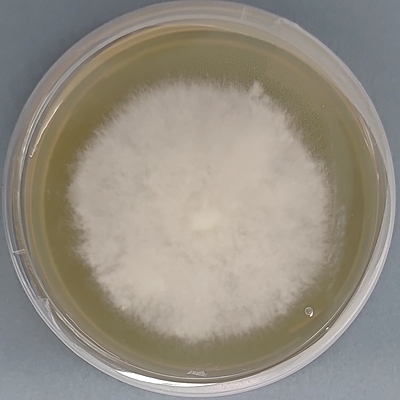
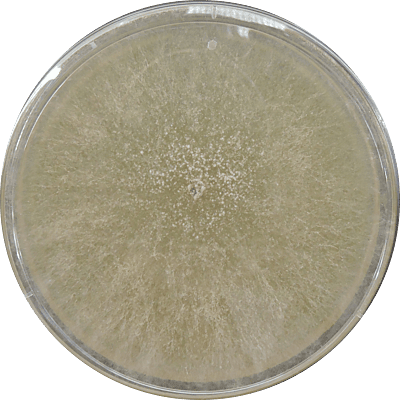
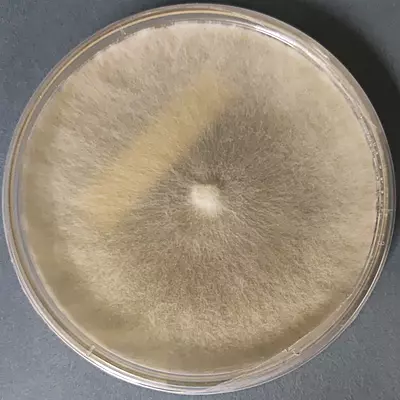
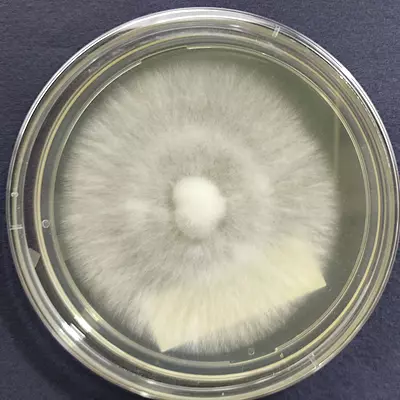
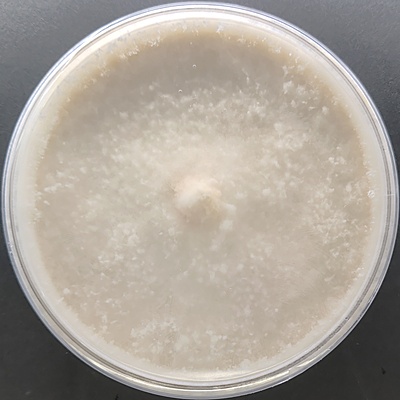
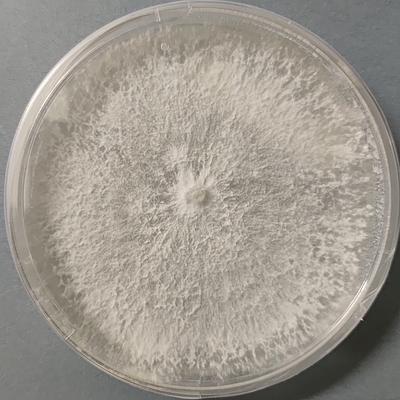
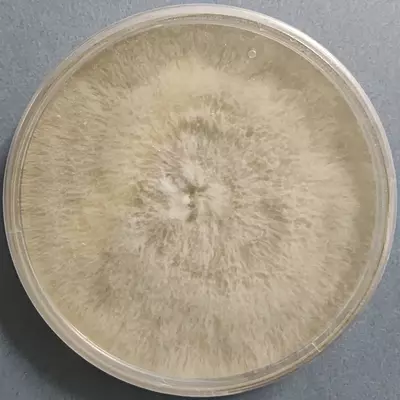
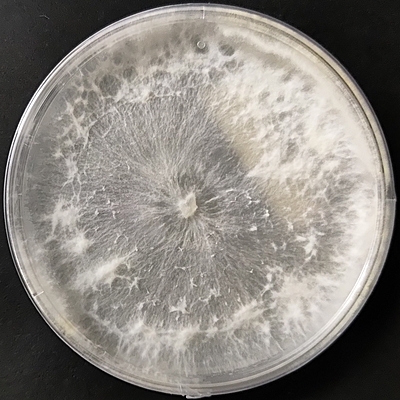
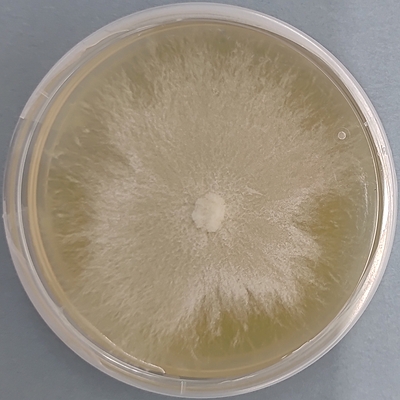
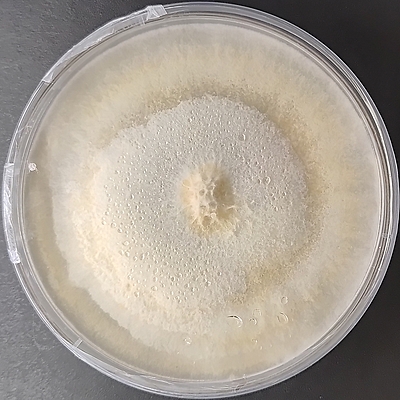
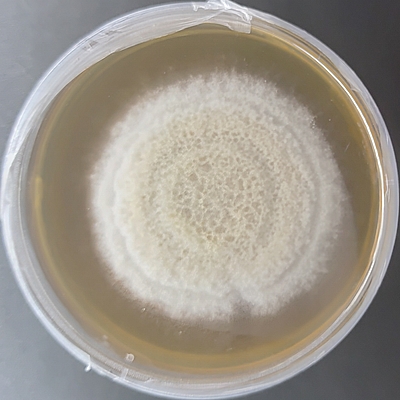

Medicinal Mushroom
Rs.1,050.00 - Rs.65,000.00
Rs.1,050.00 - Rs.65,000.00
Rs.1,125.00 - Rs.17,500.00
Medicinal Mushroom Cultures
Rs.4,500.00 Rs.5,000.00
Gourmet and Specialty Mushroom Culture
Oyster Mushroom Cultures
All Products
Rs.4,500.00 Rs.5,000.00
Rs.1,125.00 - Rs.17,500.00
Rs.1,050.00 - Rs.65,000.00
Rs.1,050.00 - Rs.65,000.00